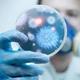
Descarga 1

-
Aristóteles y sus discípulos fundaron la escuela Alejandría.
-
Sorano de Efeso escribió un tratado de ginecología obstetricia y pediatría y sería la autoridad en obstetricia los siguientes 1500 años.
-
Galeno fue el primero en reconocer que las arterias llevan sangre y no aire y que la sangre arterial y venosa eran diferentes.
-
Albucasis el cirujano más famoso del período árabe escribió una obra conformada de 3 libros donde describió el uso del cauterio el tratamiento de heridas de fracturas y dislocaciones así como de numerosos procedimientos quirúrgicos.
A list shows items. A timeline shows sequence.
Use Timetoast to make dates, milestones, and turning points easier to understand in a clear visual format. Timetoast is a timeline maker for work, school, research, and stories.